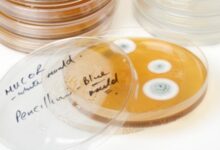

محتويات

في الحقيقة، لا يوجد إلى الآن معايير موحّدة يُمكن اتّباعها لتشخيص الإصابة بمرض الذئبة الحمراء أو الذُئبة الحمامية الشاملة (بالإنجليزية: Systemic lupus erythematosus)، لكن تُعدُّ المعايير الصادرة عن الكلية الأمريكية لأمراض الروماتيزم (بالإنجليزية: American College of Rheumatology) أكثر المعايير اتباعًا من قِبَل العديد من الأطباء؛ ويُعتقد أنّه في حال وجود أربعةٍ أو أكثر من هذه المعايير لدى الشخص في الوقت الحاضر أو في الماضي، فإنّ نسبة إصابته بمرض الذئبة الحمراء تكون مرتفعة، وفي المقابل فإنّ توفر أقل من أربعة معايير لا ينفي إصابة الشخص المعنيّ بالذئبة، ولهذا يحتاج الطبيب إلى إجراء المزيد من الاختبارات التشخيصيّة؛ من أجل تأكيد الإصابة بالمرض أو نفيها، وفيما يأتي بيانٌ لأبرز المعايير الصادرة عن الكلية الأمريكية لأمراض الروماتيزم:[١]
- التهاب المفاصل: (بالإنجليزية: Arthritis)، والذي يكون مصحوباً بألمٍ وانتفاخٍ في اثنين أو أكثر من المفاصل (*) (بالإنجليزية: Rheumatoid arthritis)، دون حدوث تلفٍ في الأنسجة المحيطة بها.
- الطفح فراشيّ الشكل: (بالإنجليزية: Butterfly rash)، حيث يُغطي الطفح الجلدي الخدين والأنف، ويكون بذلك شبيهاً بشكل الفراشة.
- الطفح القـُرْصِيّ الشكل: (بالإنجليزية: Discoid rash)، والذي يتمثّل بظهور طفحٍ جلديٍّ شبيه بشكل القرص منتفخٍ ومتقشّر، وقد يؤدي هذا الطفح إلى ترك نُدبٍ في الجلد.
- حساسية الضوء: (بالإنجليزية: Photosensitivity)، حيث قد يؤدي التعرّض لأشعة الشمس أو الأشعة فوق البنفسيجّة الأخرى (بالإنجليزية: UV light) إلى ظهور طفحٍ جلديّ أو ازدياده سوءاً.
- تقرحات الفم: وغالباً ما تكون هذه التّقرحات غير مؤلمة.
- التهاب المصليّة: (بالإنجليزية: Serositis)، والذي يتمثّل بالتهاب الغشاء المحيط بالقلب أو الرئتين، ممّا يؤدي إلى الشعور بألمٍ في الصدر تزداد شدّته عند أخذ نفَسٍ عميق.
- اضطرابات الدم: والتي تتمثل بتشخيص الإصابة السابقة بإحدى مشاكل الدم؛ مثل فقر الدم (بالإنجليزية: Anemia)، وقلّة الكريات اللمفاويّة (بالإنجليزية: Lymphocytopenia)، ونقص الكريات البيضاء (بالإنجليزية: Leukopenia)، وقلّة الصفيحات (بالإنجليزية: Thrombocytopenia).
- اضطرابات عصبيّة: مثل المعاناة من الذهان (بالإنجليزية: Psychosis)، أو النوبات التشنجية (بالإنجليزية: Seizures).
- اضطرابات الكلى: مثل خروج البروتينات وبعض البقايا الخلويّة مع البول باستمرار.
- فحص الأجسام المضادّة للنواة: ظهور نتائج غير طبيعيّة عند إجراء فحص الأجسام المضادّة للنواة (بالإنجليزية: Antinuclear antibody test)، واختصاراً (ANA).
- الاضطرابات المناعيّة: مثل ظهور نتائج إيجابيّة لاختبار الأجسام المُضادّة تجاه الحمض النووي المُضاعَف (بالإنجليزية: Anti-dsDNA)، أو أضداد الشحوم الفسفوريّة (بالإنجليزية: Antiphospholipid antibodies)، أو الأجسام المضادّة لسميث (بالإنجليزية: Anti-Smith).
قد يواجه الطبيب صعوبةً في تشخيص الإصابة بمرض الذئبة الحمراء؛ وذلك بسبب تشابه أعراض هذا المرض مع أعراض عدد من الأمراض والمشاكل الصحيّة الأخرى، إضافةً إلى اختلاف الأعراض المصاحبة للمرض من حالةٍ إلى أخرى، وكما أشرنا سابقاً فإنّه لا يوجد اختبارٌ أو تحليلٌ معيّنٍ يُمكن من خلاله تشخيص الإصابة بمرض الذئبة الحمراء، وإنّما يُشخّص بناءً على الأعراض المصاحبة له، ونتائج عددٍ من الاختبارات التشخيصيّة المختلفة؛ مثل تحاليل الدم والبول، والفحص السريريّ؛ لذلك يبدأ الطبيب بتشخيص الإصابة بالمرض من خلال الحصول على التاريخ الطبيّ للمريض، والسؤال عن وجود تاريخ عائليّ للإصابة بأحد أشكال مرض الذئبة، بالإضافة إلى السؤال عن الأعراض المصاحبة للمرض، كما يُجري الطبيب فحصًا سريريًّا للجلد؛ للتأكد من نوع الطفح الجلديّ الذي يعاني منه المريض، وفيما يأتي بيان لأبرز الاختبارات التشخيصيّة التي تساهم في تشخيص الإصابة بمرض الذئبة الحمراء:[٢][٣]
تشمل أنواع تحاليل الدم المستخدمة في تشخيص مرض الذئبة الحمراء ما يأتي:
قد يُجري الطبيب تحليل الدّم للكشف عن وجود الدلالات الحيويّة (بالإنجليزية: Biomarkers)، والدلالات الحيوية هي بروتينات، أو عوامل جينية، أو أجسام مضادّة يُعطي وجودها في الدّم فكرةً عمًا يحدث في الجسم، ومدى استجابته للعلاج في حال إعطائه، بالإضافة إلى تحديد نوع اضطراب المناعة الذاتيّة الذي يعاني منه الشخص، ومن الجدير بالذكر أنّ هذه العلامات تظهر في التحليل بغض النظر عن وجود أعراضٍ للمرض، وعلى الرغم من أنّه يصعب اعتماد وجود دلالة حيوية معيّنة لتشخيص الإصابة بالذُئبة الحمراء، إلاّ انّه من الممكن الاستعانة بتحليل الدّم للكشف عنها إلى جانب مجموعة من الفحوصات الأخرى لتشخيص الذُئبة الحمراء، ومنها ما يأتي:[٤]
- العامل المضادّ للنواة: وهو نوعٌ من الأجسام المضادة التي تهاجم نواة بعض الخلايا في الجسم، وغالباً ما تكون نتائج فحص الدّم إيجابيةً في معظم الحالات التي تكون فيها الذئبة الحمراء نشطة، أي عندما يكون المرض في طور الهبّات أو النوبات، وفي المقابل، قد تُشير النتائج الإيجابية لوجود هذا العامل في الدّم إلى الإصابة بأمراض أُخرى غير الذُئبة؛ لهذا يلجأ الأطباء لإجراء فحوصاتٍ أُخرى إلى جانب هذا الفحص لتشخيص الإصابة بالذئبة الحمراء.[٥]
- أضداد الشحوم الفسفوريّة: والتي تهاجم الدهون الفسفوريّة (بالإنجليزية: Phospholipids) في الجسم، وقد يشير وجودها في الدّم إصابة الشخص بمرض الذُئبة الحمراء، لكنها قد تظهر أيضاً لدى الأشخاص غير المصابين بالمرض، وعادة ما تُستخدم نتيجتها لتأكيد التشخيص بعد إجراء الفحوصات الأخرى.[٥]
- الأجسام المُضادّة للحمض النووي المُضاعَف: يظهر مؤشر الأجسام المُضادّة للحمض النووي المُضاعَف لدى عددٍ من الأشخاص المصابين بمرض الذئبة الحمراء، ولدى نسبةٍ قليلةٍ جداً من الأشخاص الذين لا يعانون من المرض، وقد تُشير النتيجة الإيجابية لهذا الفحص إلى خطر الإصابة بأمراض الكلى، كالتهاب الكلية الذئبيّ.[٤]
- الأجسام المضادّة لسميث: وهي أجسام مضادّة تُهاجم البروتين النوويّ الريبوزيّ (بالإنجليزية: Ribonucleoprotein) المعروف ب Sm والموجود داخل نواة الخليّة، وغالباً ما يُشير وجودها في الدّم للإصابة بمرض الذئبة الحمراء، في حين يندر وجودها لدى الأشخاص الأصحاء او المصابين بأمراض الروماتيزم الأخرى؛ لهذا السبب يُمكن استخدام فحص الكشف عن الاجسام المُّضادة لسميث لتأكيد الإصابة بمرض الذُئبة الحمراء.[٦]
- الأجسام المضادّة للبروتين النوويّ الريبوزيّ من نوع U1: (بالإنجليزية: Anti-U1RNP)، إذ وُجد أنّ هذه الأجسام تظهر في الدّم لدى العديد من الأشخاص المُصابين بالذُئبة الحمراء، لكن وجودها في الدّم قد يحدث نتيجةً للإصابة بمشاكل صحيّةٍ أُخرى؛ مثل ظاهرة رينود (بالإنجليزية: Raynaud’s phenomenon)، والتهاب المفاصل الروماتويديّ (بالإنجليزية: Rheumatoid arthritis)، والتهاب العضلات (بالإنجليزية: Polymyositis).[٤][٦]
- الأجسام المضادّة ل Ro/SSA وLa/SSB: وهي من الأجسام المُضادة لبروتينات الحمض النووي الريبوزي (*) (بالإنجليزية: Ribonucleic acid) والتي قد تظهر خلال فحص الدّم لدى عدد من الأشخاص المصابين بمرض الذئبة الحمراء، لكنها تظهر أيضاً لدى الأشخاص المصابين بأمراض مناعيّة ذاتية أُخرى؛ مثل متلازمة شوغرن (*) (بالإنجليزية: Sjögren’s syndrome).[٥]
- الأجسام المضادّة للهيستون: تُلعب الأجسام المضادّة للهيستون (بالإنجليزية: Anti-histone antibodies) دوراً في بناء المادّة الوراثيّة في الجسم، وغالباً ما تظهر هذه الأجسام في الدّم لدى الأشخاص المصابين بمرض الذئبة الناجمة عن استخدام بعض الأدوية، لكنها قد تظهر أيضاً لدى المصابين بالذُئبة الحمامية الشاملة، إلاّ أنّها لا تكفي وحدها لتأكيد تشخيص الإصابة بهذا المرض.[٦]
يُجرى فحص تعداد الدم الكامل (بالإنجليزية: Complete Blood Count)، واختصاراً CBC، للكشف عن مستويات مكونات الدّم المختلفة، بما فيها كريات الدم البيضاء المختلفة، وكريات الدّم الحمراء، والصفائح الدمويّة (بالإنجليزية: Platelet)، وكذلك يقيس نسبة الهيموغلوبين (بالإنجليزية: Hemoglobin)، وعرض توزيع كريات الدم الحمراء (بالإنجليزية: Red cell distribution width)، وحجم الخلايا المكدّسة (*) (بالإنجليزية: Haematocrit)، والحجم الكروي الوسطي (*) (بالإنجليزية: Mean corpuscular volume)، وغير ذلك؛ إذ تدل المستويات غير الطبيعية لهذه الفحوصات على وجود خلل ما في الغالب، بما في ذلك انخفاض عدد خلايا الدم البيضاء؛ فعادةً ما يُعاني المصابون بالأمراض المناعة الذاتية كالذُئبة من انخفاضٍ في عدد كريات الدّم البيضاء.[١][٧]
يقوم مبدأ اختبار سرعة ترسّب الدم (بالإنجليزية: Erythrocyte sedimentation rate) على قياس سرعة خلايا الدم الحمراء في الترسب في أنبوب الاختبار خلال ساعة واحدة، وإنّ ارتفاع مستوى هذا الاختبار عن الحدّ الطبيعي يدل على الإصابة بأحد الأمراض الصحيّة الجهازيّة أو الالتهابيّة؛ بما فيها مرض الذئبة الحمراء والعدوى، ويجدر الذكر أنّ هذا الاختبار غير مُحدّد لنوع معين من الأمراض.[٢]
يُعدّ اختبار البروتين المتفاعل-C (بالإنجليزية: C-Reactive Protein)، واختصاراً CRP، من الاختبارات المُستخدمة للكشف عن وجود التهابٍ في الجسم، لكنه يُستخدم بشكلٍ رئيسي لمراقبة نشاط الأمراض في الجسم، بما فيها الذئبة الحمراء، ومن الجدير بالذكر أنّ مستويات البروتين المتفاعل-C قد تكون مرتفعةً لدى الأشخاص المصابين بالعدوى أو الذين يُعانون من السُّمنة.[٧]
يتمّ إجراء تحليل كيمياء الدم (بالإنجليزية: Chemistry Panel) للكشف عن وظائف عدّة أعضاءٍ في الجسم، بما فيها وظائف الكلى والكبد، بالإضافة إلى قياس نسبة السكّر في الدم، والكولسترول، والشحوم الثلاثيّة (بالإنجليزية: Triglyceride)، والكهارل (بالإنجليزية: Electrolytes)؛ إذ قد يُشير وجود خللٍ في هذه الفحوصات إلى تتطور بعض المضاعفات الصحيّة لدى الشخص المُصاب بالذئُبة الحمراء.[٥]
قد يُؤثر مرض الذُئبة الحمراء في الكلى في بعض الحالات؛ لهذا قد يُوصي الطبيب بإجراء عددٍ من التحاليل البوليّة وبشكلٍ دوريّ؛ حتى يتمكن من تشخيص ومراقبة تأثير المرض في الكلى عن كثب، وفيما يأتي بيان لأبرز هذه التحاليل:[٧][٨]
- تحليل البول: (بالإنجليزية: Urinalysis)، المُستخدم للكشف عن وجود كريات الدم البيضاء أو الحمراء، أو البروتين في البول، حيث يعدّ وجودها مؤشراً على إصابة الكلى.
- معدّل الترشيح الكبيبيّ والبيلة البروتينية: إذ يُستخدم معدّل الترشيح الكبيبيّ (بالإنجليزية: Glomerular Filtration Rate) والبيلة البروتينية (بالإنجليزية: Proteinuria) للكشف عن كفاءة الكلى في تنقية الدم.
- تحليل نسبة البروتين/الكرياتينين: (بالإنجليزية: Protein/Creatinine Ratio)، والذي يُستخدم لمعرفة ما إذا كانت نسبة البروتين في البول أكثر من الطبيعي.
- تحاليل أخرى: مثل تحليل الكشف عن وجود بكتيريا في البول، وتحليل درجة حموضة البول.
قد يُوصي الطبيب بإجراء عددٍ من الفحوصات التصويريّة، خاصةً في حال ظهور أعراضٍ تُشير إلى تضرر بعض الأعضاء الداخلية الذي يُحتمل أن يكون ناجمًا عن الإصابة بالذئبة، ومن هذه الفحوصات نذكر ما يأتي:[١]
- التصوير بالأشعّة السينيّة: (بالإنجليزية: X-ray)، والذي يُستخدم لتصوير منطقة الصدر، للكشف عمّا إن كانت هناك علاماتٌ تُشير إلى تضخّم عضلة القلب، أو وجود التهابٍ في الرئتين، أو سوائل في أيّ منهما.
- التصوير بالأشعّة فوق الصوتيّة: (بالإنجليزية: Ultrasound)، والذي قد يلجأ إليه الطبيب للكشف عن وجود انسدادٍ أو تضخّمٍ في الكلى، أو لمعرفة سبب ألم المفاصل الشديد.
- تخطيط صدى القلب: (بالإنجليزية: Echocardiography)، والذي يساعد على الكشف عن اضطراباتٍ القلب وصمّاماته.
- التصوير بالرنين المغناطيسيّ: (بالإنجليزية: Magnetic Resonance Imaging)، واختصاراً MRI، والذي يُستخدم للكشف عن سلامة الدماغ في حال ظهور بعض الأعراض المرتبطة به؛ مثل اضطراب الذاكرة.
- التصوير الطبقيّ المحوريّ: (بالإنجليزية: Computed Tomography Scan)، واختصاراً CT Scan، والذي يُجرى للكشف عن بعض الاضطربات الداخليّة؛ مثل أمراض الرئتين، والتهاب البنكرياس (بالإنجليزية: Pancreatitis) في حال الشعور بألم في البطن.
يُلجأ لأخذ خزعة من الكلى في حال الشك بالإصابة بالتهاب الكلية الذئبي، وخاصة في حال ظهور أعراض أو علامات تدل على ذلك، ولا سيّما في المرة الأولى من الإصابة، ويقوم مبدأ الخزعة على أخذ عينة من النسيج المعنيّ؛ فمثلًا في حال الرغبة في أخذ خزعة من الكلية، فإنّ عينة تُؤخذ منها بواسطة إبرة رفيعة في الغالب.[٢][٩]
مرض الذُئبة الحمراء هو أحد أمراض المناعة الذاتيّة (بالإنجليزية: Autoimmune disease) التي يُهاجم فيها الجهاز المناعيّ أنسجة وأعضاء الجسم المختلفة،[١٠] كالمفاصل، والجلد، والكلى، وخلايا الدّم، والدّماغ، والقلب، والرئتين، ممّا يؤدي إلى حدوث التهابٍ في هذه الأجزاء،[١١] وفي هذا السياق يُشار إلى أنّ الذئبة الحمراء هي أحد أنواع الذئبة وأكثرها شيوعًا، إذ إنّ لمرض الذئبة أربعة أنواع رئيسية، وهي الذئبة الحمراء، والذئبة الحُمامية الجلدية (بالإنجليزية: Cutaneous lupus erythematosus)، والذئبة الحمامية المُحدَثة بالأدوية (بالإنجليزية: Drug-induced lupus erythematosus)، والذئبة الوليدية (بالإنجليزية: Neonatal lupus).[١٢]
لأنّ الذئبة قد تؤثر في العديد من أعضاء الجسم، فإنّ الأعراض التي تظهر على المصاب تختلف باختلاف العضو المتأثر، ومن العلامات المميزة التي قد تظهر لدى الكثير من المصابين الطفح الجلديٍّ في الوجه الذي يشمل كلا الخدين ليمثّل شكلاً شبيهاً بأجنحة الفراشة، وبشكلٍ عامٍ، فإنّ أعراض المرض الأخرى تختلف من شخصٍ إلى آخر، كما قد تظهر هذه الأعراض بشكلٍ مفاجئٍ أو تدريجيّ، وقد تستمر لفترةٍ مؤقتةٍ أو دائمةٍ، ولكن غالباً ما تظهر الأعراض على شكل هبّاتٍ متفرقةٍ تتخللها فتراتٌ من الفتور التي تختفي فيها الأعراض أو على الأقل تخفّ شدتها، وتجدر الإشارة إلى أنّ الأشخاص الذين لديهم استعدادٌ وراثيٌّ للذُئبة الحمراء منذ الولادة قد يُصابون بها في حال تعرّضهم لبعض المحفّزات، مثل: الإصابة ببعض أنواع العدوى، واستخدام بعض الأدوية، والتعرّض لأشعّة الشمس، وفي الحقيقة، لم يتمكّن العلماء من تطوير علاجٍ يُساهم في التعافي التامّ من المرض إلى الآن، لكن يتوفر عدد من العلاجات التي يُمكن وصفها للسيطرة على أعراض المرض.[١١]
ولمعرفة المزيد عن مرض الذئبة الحمراء يمكن قراءة المقال الآتي: (ما هي الذئبة الحمراء).
الهوامش:
(*) متلازمة شوغرن: تُمثل أحد أمراض المناعة الذاتية التي يُهاجم فيها جهاز المناعة أجزاء مُعينة من الجسم عن طريق الخطأ؛ تحديداً الغُدد التي تُصنّع الدموع واللّعاب.[١٣]
(*) التهاب المفاصل الروماتيدي: يُمثل أحدّ أمراض المناعة الذاتية طويلة الأمد والتقدمية، إذ يتسبّب هذا المرض بحدوث التهاب، وانتفاخ، وألم داخل المفاصل وحوله، وقد يؤثر أيضاً في أعضاء الجسم الأخرى.[١٤]
(*) ظاهرة رينود: تتمثل بحدوث تشنّجات مُتكررة في الأوعية الدموية الخاصّة بأصابع اليدين والأقدام، ويحدث ذلك في العادة استجابةً للتوتر أو التعرّض للبرد.[١٥]
(*) الحمض النووي الرايبوزي: يُمثل المُنتج الرئيسي للتعبير الجيني وله دور مهمّ في الوظائف الخلوية؛ بما في ذلك تصنيع البروتينات، ويحتوي هذا الحمض النووي في تركيبته على سكّر الريبوز.[١٦]
(*) حجم الخلايا المكدّسة: النسبة المئوية لخلايا الدم الحمراء في الدم.[١٧]
(*) الحجم الكروي الوسطي: متوسط حجم خلايا الدم الحمراء في عينة الدم.[١٨]
للتعرف على المزيد من المعلومات عن مرض الذئبة الحمراء شاهد هذا الفيديو.
- ^ أ ب ت Jeri Jewett-Tennant (1-9-2019), “How Lupus Is Diagnosed”، www.verywellhealth.com, Retrieved 12-9-2019. Edited.
- ^ أ ب ت “Lupus Diagnosis & treatment”, www.mayoclinic.org,25-10-2017، Retrieved 12-9-2019. Edited.
- ↑ “Diagnosing Cutaneous Lupus”, nyulangone.org, Retrieved 12-9-2019. Edited.
- ^ أ ب ت Yvette Brazier, “What is lupus”، www.medicalnewstoday.com, Retrieved 12-9-2019. Edited.
- ^ أ ب ت ث “Lab Tests for Lupus”, www.webmd.com, Retrieved 12-9-2019. Edited.
- ^ أ ب ت “Lupus Blood Tests”, www.hopkinslupus.org, Retrieved 12-9-2019. Edited.
- ^ أ ب ت “Understanding Laboratory Tests and Results for Lupus (SLE)”, www.hss.edu, Retrieved 12-9-2019. Edited.
- ↑ “Which urine tests are used for lupus?”, www.webmd.com, Retrieved 12-9-2019. Edited.
- ↑ “Lupus Nephritis”, emedicine.medscape.com, Retrieved 12-9-2019. Edited.
- ↑ “Systemic lupus erythematosus”, medlineplus.gov, Retrieved 12-9-2019. Edited.
- ^ أ ب “Lupus Symptoms & causes”, www.mayoclinic.org,25-10-2017, Retrieved 12-9-2019. Edited.
- ↑ “The four different types of lupus”, www.lupus.org, Retrieved 12-9-2019. Edited.
- ↑ “sjogrens syndrome”, medlineplus.gov, Retrieved 21-11-2019. Edited.
- ↑ “What is rheumatoid arthritis?”, www.medicalnewstoday.com, Retrieved 23-11-2019. Edited.
- ↑ “Raynaud Phenomenon”, www.emedicine.medscape.com, Retrieved 23-11-2019. Edited.
- ↑ “ribonucleic acid”, www.sciencedirect.com, Retrieved 23-11-2019. Edited.
- ↑ “Hematocrit (Blood Test)”, www.emedicinehealth.com, Retrieved 23-11-2019. Edited.
- ↑ “Mean Corpuscular Volume (MCV) “, emedicine.medscape.com, Retrieved 23-11-2019. Edited.